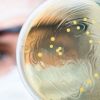

-
 +4 +1
+4 +1In Pursuit of Chinese Scapegoats, Media Reject Life-Saving Lessons
We are barely a few months into the year, but it is already clear that the coronavirus will be 2020’s defining event in media and politics. For weeks, conservative media echoed the explicit Trump line that the reaction to COVID-19 was a liberal “hoax” weaponized against the White House. Recent Presidential Medal of Freedom recipient Rush Limbaugh has been pouring scorn on the media “hysteria”: Extolling how the market was “roaring” (Rush Limbaugh Show, 3/2/20), he claimed it was nothing to worry about. “This virus is the common cold,” he confidently predicted (3/11/20).
-
 +7 +1
+7 +1Fox News Staffers Got Coronavirus After Anchors Downplayed the Pandemic
Despite anchors claiming the outbreak wasn't a big deal, Fox News headquarters has been taking preventative measures since February.
-
 +15 +1
+15 +1Fox guest Jerry Falwell Jr. speculates that North Korea “got together with China” to create coronavirus
Fox & Friends hosts don't dispute him at all
-
 +19 +1
+19 +1What It Took for a Fox News Psychiatrist to Finally Lose His License
Keith Ablow was a popular fixture on the cable channel until 2017, and a high-profile therapist. He left a trail of vulnerable female patients who claim he abused them.
-
 +15 +1
+15 +1What Does Tucker Carlson Believe?
Tucker Carlson does not think he is an “especially” good person. He knows he can “get mad” and “make a mistake,” that he can “overstate” things as a result of getting “caught up” in his own rhetoric. He also knows he can sometimes get “self-righteous,” and this, as we speak on the set of his Fox News show on a recent Friday, seems to bother him the most. Because it is everything Carlson disdains in others—the elitist sensibility that, in his mind, leads figures such as former United Nations Ambassador Samantha Power to espouse a worldview whose essence, as he puts it, is “I’m a really good person, and you’re not.”
-
 +31 +1
+31 +1The 58 most bananas lines from Donald Trump's Friday 'Fox & Friends' interview
Looking for a shelter in the storm amid one of the most damaging weeks of his presidency, President Donald Trump phoned in for a nearly hour-long monologue -- er, interview with "Fox & Friends."
-
 +11 +1
+11 +1Appeals court rules parents of slain DNC staffer can sue Fox News
The 2nd U.S. Circuit Court of Appeals in Manhattan said Joel and Mary Rich, of Omaha, Nebraska, had sufficiently alleged they were subjected to emotional distress after their son, 27-year-old Seth Rich, was shot and killed in 2016 in Washington, D.C., in what authorities have said was a botched robbery near his home.
-
 +18 +1
+18 +1Sarah Huckabee Sanders Will Join Fox News as Contributor
Sarah Huckabee Sanders, one of the more controversial holders of the office of White House Press Secretary in recent memory, will join Fox News Channel as a contributor.
-
 +5 +1
+5 +1Tucker Carlson's Show Bled 70 Advertisers in Less Than a Year
Even more advertisers have abandoned the Fox News host after he called white supremacy "a hoax."
-
 +29 +1
+29 +1Hannity Says It’s ‘Despicable’ to Call for Political Opponents to Be ‘Locked Up’
‘Based on no actual crimes, she wants a political opponent locked up in prison. Umm, that happens in banana republics. Beyond despicable behavior.’
-
 +31 +1
+31 +1What I’ve Learned From People Whose Loved Ones Were Transformed by Fox News
I’ve been collecting stories from people who feel as though their loved ones were changed by Fox News. They don’t have happy endings.
-
 +3 +1
+3 +1Tucker Carlson Seems to Have Some Fun Thoughts About Women, Underage Girls, & Statutory Rape
Fox News host Tucker Carlson is many things: a blowhard, a fear-mongering racist, an overgrown frat boy with a giant, empty head. He is also, apparently, the type of man who goes onto shock jock radio programs to talk about how hot it is to imagine 14-year-old girls sexually experimenting with each other. Carlson is a very multifaceted person.
-
 +19 +1
+19 +1It’s time — high time — to take Fox News’s destructive role in America seriously
Chris Wallace is an exceptional interviewer, and Shepard Smith and Bret Baier are reality-based news anchors. Now that we’ve got that out of the way, let’s talk about the overall problem of Fox News, which started out with bad intentions in 1996 and has swiftly devolved into what often amounts to a propaganda network for a dishonest president and his allies.
-
 +46 +1
+46 +1The Making of the Fox News White House
Fox News has always been partisan. But has it become propaganda?
-
+15 +1
+15 +1‘Fox News’ Host Says He Hasn’t Washed His Hands In A Decade Because ‘Germs Are Not A Real Thing’
Fox News host Pete Hegseth said Sunday that he has not washed his hands in a decade because “germs are not a real thing,” Raw Story reports. Hegseth made the statement live on air during a Fox & Friends episode. His co-host, Jedediah Bila, started a conversation about pizza — yesterday was National Pizza Day — explaining that Hegseth had been munching on old pizza while on the set.
-
 +2 +1
+2 +1MSNBC tops Fox News for the first time since 2000
MSNBC topped Fox News in total viewers during the week of Dec. 17 for the first time since 2000 as its flagship "The Rachel Maddow Show" ended the week as cable news' most-watched program. (Update: Fox News notes that Sean Hannity, who is opposite Maddow at 9 p.m. ET, has been out for the holidays since Dec. 14.)
-
 +4 +1
+4 +1Advertisers are dropping Tucker Carlson's Fox News show after he said immigration makes the US 'dirtier'
Advertisers are abandoning Fox News host Tucker Carlson's show after he suggested that immigrants are making the US "dirtier." At least five advertisers are leaving "Tucker Carlson Tonight" or confirmed that they are no longer advertising with the show after his segment on immigration last Thursday. Carlson said that the US needs more "scientists and engineers" for increasingly automated and tech-centered jobs.
-
 +11 +1
+11 +1Tucker Carlson suggested immigrants make the U.S. ‘dirtier’ — and it cost Fox News an advertiser
In less than three minutes, Tucker Carlson suggested immigrants make the United States “dirtier,” contradicted himself on their values and gushed over Mexicans frustrated with Central American caravans. The opening tear cost his Fox News show an advertiser, at least for now. Few advocates, if any, argue the economic merit of immigration, Carlson said in his opening monologue Thursday evening. The nation needs skilled workers, but Carlson said that is not who arrives here. (Fact check: Not true.)
-
 +14 +1
+14 +1Fox News contributor Tomi Lahren says seeing migrants get hit with tear gas was the "highlight" of her Thanksgiving
Border agents used the gas on migrants who tried to rush the border on Sunday in Tijuana.
-
 +22 +1
+22 +1A Tale Of Two Email Controversies On Fox News
Submit a link
Start a discussion




















